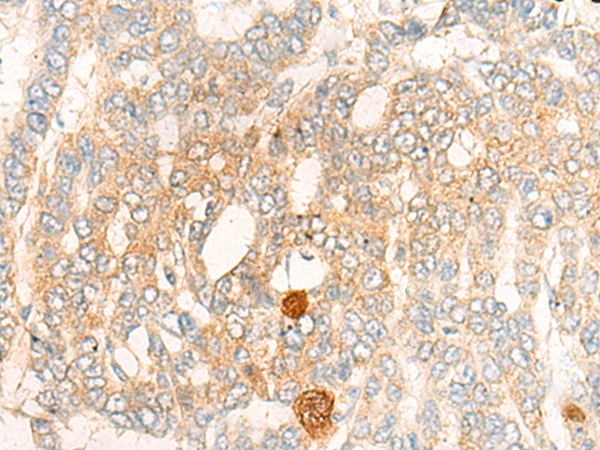

|
Background: |
Synthetic peptide of human DBT |
|
Applications: |
ELISA, WB, IHC |
|
Name of antibody: |
DBT |
|
Immunogen: |
Synthetic peptide of human DBT |
|
Full name: |
dihydrolipoamide branched chain transacylase E2 |
|
Synonyms: |
E2; E2B; BCATE2; BCKADE2; BCKAD-E2; BCOADC-E2 |
|
SwissProt: |
P11182 |
|
ELISA Recommended dilution: |
5000-10000 |
|
IHC positive control: |
Human liver cancer; |
|
IHC Recommend dilution: |
10-50 |
|
WB Predicted band size: |
53 kDa |
|
WB Positive control: |
Mouse liver tissue lysate |
|
WB Recommended dilution: |
200-1000 |
購物車
幫助
021-54845833/15800441009
